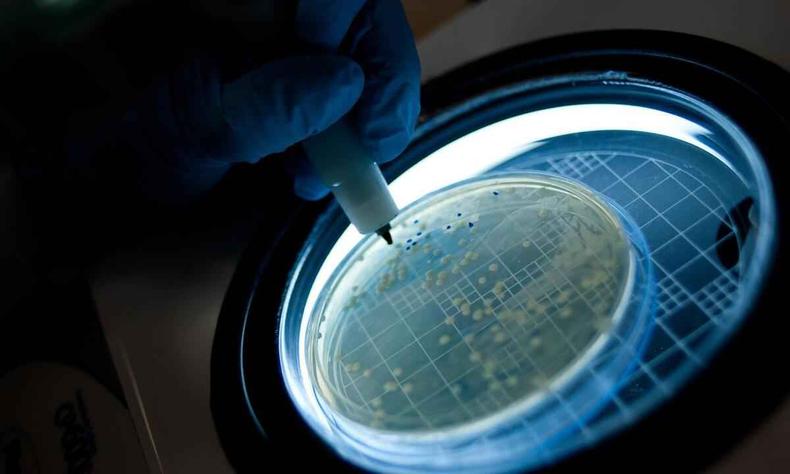

Os dados foram compilados pela Ag�ncia Bori, servi�o que conecta a imprensa e a ci�ncia brasileira, e pela Elsevier, uma editora de publica��es cient�ficas. De in�cio, foi definido que entrariam no levantamento somente aqueles pa�ses que publicaram mais de 10 mil artigos em 2021 –no caso, 51 na��es. Elas j� representam cerca de 95% de toda a produ��o cient�fica mundial.
Optou-se pela base de dados Scopus, da Elsevier, para acessar o montante de artigos e seus respectivos pa�ses de publica��o. Al�m do Brasil, outros 22 tiveram queda na produ��o cient�fica. A contra��o aconteceu tamb�m em pa�ses ricos e com fortes institui��es de pesquisa, como EUA, Inglaterra e Fran�a.
Mas o que chama a aten��o de Est�v�o Gamba, cientometrista da Ag�ncia Bori e um dos respons�veis pelo levantamento, � que foi o primeiro ano que ocorreu uma queda na produ��o de artigos brasileiros. "Desde 1996, que � quando essa base da Elsevier foi criada, � a primeira queda do Brasil."Em 2020, primeiro ano da pandemia de Covid-19, foram cerca de 77 mil artigos publicados nacionalmente. Um ano depois, esse n�mero subiu para 80 mil e, em 2022, caiu para 74 mil. Gamba explica que o pa�s sofria uma desacelera��o no volume de textos publicados nos per�odos cient�ficos, mas ainda n�o tinha registrado uma contra��o comparada ao ano anterior –sempre subiu, mesmo que pouco.
Outro aspecto preocupante � que a diminui��o de 7,4% foi a maior registrada em todos os pa�ses. Somente a Ucr�nia tamb�m chegou a esse percentual, mas o pa�s do leste europeu esteve em guerra por quase todo 2022, o que pode explicar a queda.
No caso do Brasil, existem hip�teses diferentes para dar conta do encolhimento. Um deles, que tamb�m impactou outros pa�ses, foi a pandemia de Covid-19. Al�m desse, a falta de financiamento que a ci�ncia brasileira passou nos �ltimos anos causa um efeito negativo no desenvolvimento de novos artigos. "N�o se faz pesquisa sem dinheiro", resume Gamba.
E a redu��o nacional pode continuar nos pr�ximos anos. Isso porque a realiza��o de uma pesquisa demora, juntamente com sua publica��o. Gamba explica que a queda de 2022, por exemplo, � reflexo de pesquisas que deixaram de ser desenvolvidas em meados dos anos de 2019 e 2020.
Como a pandemia se arrastou por outros anos e tamb�m houve contingenciamento de verba, a produ��o nacional de artigos deve sofrer ainda. "A gente ainda vai continuar possivelmente observando a queda", diz Gamba.
Mas a n�vel global a produ��o de artigos na totalidade cresceu. O aumento foi 6,1% em 2022 em compara��o ao ano anterior. China, EUA e �ndia s�o os tr�s principais produtores de pesquisa –o Brasil ocupa a 14ª posi��o, mesma que j� tinha em 2021.
OUTROS INDICADORES
A ci�ncia de um pa�s ou de uma institui��o n�o � medida somente pela quantidade de artigos veiculados em peri�dicos. Outro indicador importante � a qualidade dessas publica��es, que pode ser acessada, por exemplo, pelo volume de cita��es feitas em outros estudos. Quanto mais um artigo � citado, maior sua qualidade e relev�ncia na �rea de pesquisa.
Por enquanto, o levantamento rec�m-divulgado n�o compilou informa��es sobre a qualidade, mas isso j� est� no horizonte da equipe, afirma Gamba. "A gente s� est� vendo a queda na produ��o, mas pode ter ca�do tamb�m a qualidade dos artigos", conclui.
